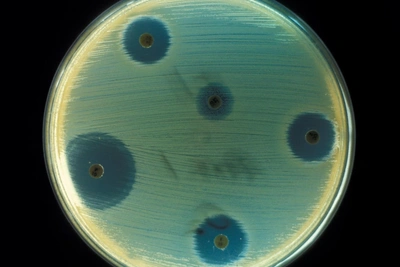
Лекция Водовозова: вся правда об антибиотиках

Инспектор ДПС на операции после удара пассажира в Петербурге
Сотрудника дорожно-патрульной службы госпитализировали с серьёзными травмами после конфликта на месте ДТП. Нападавший задержан, против него могут возбудить уголовное дело.
23 января, 2026, 16:23 1
23 января инспектора дорожно-патрульной службы в Санкт-Петербурге доставили в больницу для хирургического вмешательства. Поводом стала агрессия пассажира автомобиля Mercedes, который ударил сотрудника по лицу во время разбирательства на месте аварии.
По предварительной информации, у пострадавшего диагностировали закрытую черепно-мозговую травму, сотрясение головного мозга, кровоподтёки на веках и носу, а также перелом стенок глазницы.
Происшествие случилось около 10:30 утра на проспекте Шаумяна. Полицейские прибыли на место столкновения Mercedes-Benz C-класса и Volkswagen Polo. После того как Volkswagen врезался в стоявший Mercedes, пассажир последнего — 33-летний гражданин Азербайджана — выбежал на проезжую часть, устроил скандал и разбил лобовое стекло машины виновницы. В ходе конфликта он требовал от сотрудников ДПС не оформлять документы, а затем нанёс инспектору сильный удар в лицо.
Агрессора задержали. В отношении него уже составлен протокол о мелком хулиганстве, а правоохранители решают вопрос о возбуждении уголовного дела.
Читайте также